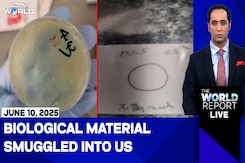

Los Angeles Protest
-
{
- All
- News
- Videos
-

Iranians Across US Take To The Streets For - And Against - Strikes
- Sunday March 1, 2026
- World News | Agence France-Presse
Iranians in Los Angeles took to the streets to cheer the death of supreme leader Ayatollah Ali Khamenei Saturday, joining protests in support of the US and Israeli strikes on Iran across the North American diaspora.
-
 www.ndtv.com
www.ndtv.com
-

On Camera, Truck Drives Into Crowd Supporting Iranian Protesters In US
- Monday January 12, 2026
- World News | Edited by Manjiri Chitre
A video showed the protesters swarming the truck, throwing punches at the driver, and thrusting flagpoles through the driver's side window.
-
 www.ndtv.com
www.ndtv.com
-

Trump's Los Angeles Troop Deployment Violated Federal Law: Judge
- Wednesday September 3, 2025
- World News | Bloomberg
President Donald Trump violated federal law by deploying National Guard troops and US Marines to carry out local law enforcement in Los Angeles over the summer as protests raged against his immigration crackdown, a judge ruled.
-
 www.ndtv.com
www.ndtv.com
-

President Trump Sent Military To 'Silence' Los Angeles Protests: California
- Wednesday August 13, 2025
- World News | Reuters
The US government's unprecedented use of National Guard troops in Los Angeles to protect officers carrying out President Donald Trump's immigration crackdown was illegal and should be ended, a lawyer for the state of California told a federal judge.
-
 www.ndtv.com
www.ndtv.com
-

Trial Begins Over Trump's Deployment Of National Guard In Los Angeles
- Tuesday August 12, 2025
- World News | Associated Press
The Los Angeles field office director for the Department of Homeland Security testified on Monday that Immigration and Customs Enforcement officers desperately needed the help of military personnel in carrying out arrests.
-
 www.ndtv.com
www.ndtv.com
-

Trump Administration Froze $584 Million In Federal Funding: California University
- Thursday August 7, 2025
- World News | Reuters
President Donald Trump's administration has frozen $584 million in federal funding for the University of California, Los Angeles, UCLA said on Wednesday after the government reprimanded the university over pro-Palestinian protests.
-
 www.ndtv.com
www.ndtv.com
-

Stanford University Lays Off 363 Employees Due To Funding Cuts By Trump
- Wednesday August 6, 2025
- World News | Reuters
Stanford University said on Tuesday it has laid off over 360 employees, citing budget constraints that it attributed to the federal funding policies of US President Donald Trump.
-
 www.ndtv.com
www.ndtv.com
-

Pentagon Withdraws 700 Marines From Los Angeles
- Tuesday July 22, 2025
- World News | AP
The Pentagon ordered the U.S. Marines to leave Los Angeles on Monday, more than a month after President Donald Trump deployed them to the city against the objections of local leaders.
-
 www.ndtv.com
www.ndtv.com
-

Pentagon Ends Deployment Of 2,000 National Guard In Los Angeles
- Wednesday July 16, 2025
- World News | AP
The Pentagon said Tuesday it is ending the deployment of 2,000 National Guard troops in Los Angeles, accounting for nearly half of the soldiers sent to the city to deal with protests over the Trump administration's immigration crackdown.
-
 www.ndtv.com
www.ndtv.com
-

Night Curfew To Continue Amid Los Angeles Protests, Says Mayor
- Monday June 16, 2025
- World News | Agence France-Presse
A nightly curfew in Los Angeles will continue for "a couple more days," Mayor Karen Bass said Sunday, the ninth day of protests that have seen US President Donald Trump launch a military-backed crackdown.
-
 www.ndtv.com
www.ndtv.com
-

"Get The Job Done": Trump Says Expand Efforts To Deport Illegal Immigrants
- Monday June 16, 2025
- World News | Reuters
President Donald Trump on Sunday said efforts to deport people who are illegally in the United States must be expanded, including from cities such as Los Angeles, Chicago and New York, which have seen protests since immigration raids were ramped up.
-
 www.ndtv.com
www.ndtv.com
-

Balloons, Bubbles, Tear Gas: How LA Anti-Trump Protests Turned Chaotic
- Sunday June 15, 2025
- World News | Agence France-Presse
For hours, thousands of people in Los Angeles peacefully celebrated their defiance of US President Donald Trump Saturday with music, marching, bubbles and balloons -- then police unexpectedly moved in, and chaos and confusion broke out.
-
 www.ndtv.com
www.ndtv.com
-

US Appeals Court Allows Trump To Keep National Guard In Los Angeles
- Friday June 13, 2025
- World News | Reuters
A US appeals court on Thursday allowed Trump to maintain his deployment of National Guard troops in Los Angeles amid protests over stepped-up immigration enforcement, temporarily pausing a lower court ruling that blocked the mobilisation.
-
 www.ndtv.com
www.ndtv.com
-

Watch: California Senator Handcuffed, Forcibly Removed From LA Press Conference
- Friday June 13, 2025
- World News | Agence France-Presse
California's stand-off with President Donald Trump's administration ratcheted up Thursday, after a sitting US senator was handcuffed and forcibly removed from a press conference on controversial immigration raids that have spurred days of protests.
-
 www.ndtv.com
www.ndtv.com
-

Amid Unrest, Trump Sends More US Troops To LA Than In Iraq, Syria Combined
- Thursday June 12, 2025
- World News | Edited by Sanstuti Nath
US President Donald Trump has reportedly sent more American troops to the city of Los Angeles (LA) in California-- to curb the protests against his harsh immigration policies -- than those deployed in Iraq and Syria by Washington.
-
 www.ndtv.com
www.ndtv.com
-

Iranians Across US Take To The Streets For - And Against - Strikes
- Sunday March 1, 2026
- World News | Agence France-Presse
Iranians in Los Angeles took to the streets to cheer the death of supreme leader Ayatollah Ali Khamenei Saturday, joining protests in support of the US and Israeli strikes on Iran across the North American diaspora.
-
 www.ndtv.com
www.ndtv.com
-

On Camera, Truck Drives Into Crowd Supporting Iranian Protesters In US
- Monday January 12, 2026
- World News | Edited by Manjiri Chitre
A video showed the protesters swarming the truck, throwing punches at the driver, and thrusting flagpoles through the driver's side window.
-
 www.ndtv.com
www.ndtv.com
-

Trump's Los Angeles Troop Deployment Violated Federal Law: Judge
- Wednesday September 3, 2025
- World News | Bloomberg
President Donald Trump violated federal law by deploying National Guard troops and US Marines to carry out local law enforcement in Los Angeles over the summer as protests raged against his immigration crackdown, a judge ruled.
-
 www.ndtv.com
www.ndtv.com
-

President Trump Sent Military To 'Silence' Los Angeles Protests: California
- Wednesday August 13, 2025
- World News | Reuters
The US government's unprecedented use of National Guard troops in Los Angeles to protect officers carrying out President Donald Trump's immigration crackdown was illegal and should be ended, a lawyer for the state of California told a federal judge.
-
 www.ndtv.com
www.ndtv.com
-

Trial Begins Over Trump's Deployment Of National Guard In Los Angeles
- Tuesday August 12, 2025
- World News | Associated Press
The Los Angeles field office director for the Department of Homeland Security testified on Monday that Immigration and Customs Enforcement officers desperately needed the help of military personnel in carrying out arrests.
-
 www.ndtv.com
www.ndtv.com
-

Trump Administration Froze $584 Million In Federal Funding: California University
- Thursday August 7, 2025
- World News | Reuters
President Donald Trump's administration has frozen $584 million in federal funding for the University of California, Los Angeles, UCLA said on Wednesday after the government reprimanded the university over pro-Palestinian protests.
-
 www.ndtv.com
www.ndtv.com
-

Stanford University Lays Off 363 Employees Due To Funding Cuts By Trump
- Wednesday August 6, 2025
- World News | Reuters
Stanford University said on Tuesday it has laid off over 360 employees, citing budget constraints that it attributed to the federal funding policies of US President Donald Trump.
-
 www.ndtv.com
www.ndtv.com
-

Pentagon Withdraws 700 Marines From Los Angeles
- Tuesday July 22, 2025
- World News | AP
The Pentagon ordered the U.S. Marines to leave Los Angeles on Monday, more than a month after President Donald Trump deployed them to the city against the objections of local leaders.
-
 www.ndtv.com
www.ndtv.com
-

Pentagon Ends Deployment Of 2,000 National Guard In Los Angeles
- Wednesday July 16, 2025
- World News | AP
The Pentagon said Tuesday it is ending the deployment of 2,000 National Guard troops in Los Angeles, accounting for nearly half of the soldiers sent to the city to deal with protests over the Trump administration's immigration crackdown.
-
 www.ndtv.com
www.ndtv.com
-

Night Curfew To Continue Amid Los Angeles Protests, Says Mayor
- Monday June 16, 2025
- World News | Agence France-Presse
A nightly curfew in Los Angeles will continue for "a couple more days," Mayor Karen Bass said Sunday, the ninth day of protests that have seen US President Donald Trump launch a military-backed crackdown.
-
 www.ndtv.com
www.ndtv.com
-

"Get The Job Done": Trump Says Expand Efforts To Deport Illegal Immigrants
- Monday June 16, 2025
- World News | Reuters
President Donald Trump on Sunday said efforts to deport people who are illegally in the United States must be expanded, including from cities such as Los Angeles, Chicago and New York, which have seen protests since immigration raids were ramped up.
-
 www.ndtv.com
www.ndtv.com
-

Balloons, Bubbles, Tear Gas: How LA Anti-Trump Protests Turned Chaotic
- Sunday June 15, 2025
- World News | Agence France-Presse
For hours, thousands of people in Los Angeles peacefully celebrated their defiance of US President Donald Trump Saturday with music, marching, bubbles and balloons -- then police unexpectedly moved in, and chaos and confusion broke out.
-
 www.ndtv.com
www.ndtv.com
-

US Appeals Court Allows Trump To Keep National Guard In Los Angeles
- Friday June 13, 2025
- World News | Reuters
A US appeals court on Thursday allowed Trump to maintain his deployment of National Guard troops in Los Angeles amid protests over stepped-up immigration enforcement, temporarily pausing a lower court ruling that blocked the mobilisation.
-
 www.ndtv.com
www.ndtv.com
-

Watch: California Senator Handcuffed, Forcibly Removed From LA Press Conference
- Friday June 13, 2025
- World News | Agence France-Presse
California's stand-off with President Donald Trump's administration ratcheted up Thursday, after a sitting US senator was handcuffed and forcibly removed from a press conference on controversial immigration raids that have spurred days of protests.
-
 www.ndtv.com
www.ndtv.com
-

Amid Unrest, Trump Sends More US Troops To LA Than In Iraq, Syria Combined
- Thursday June 12, 2025
- World News | Edited by Sanstuti Nath
US President Donald Trump has reportedly sent more American troops to the city of Los Angeles (LA) in California-- to curb the protests against his harsh immigration policies -- than those deployed in Iraq and Syria by Washington.
-
 www.ndtv.com
www.ndtv.com